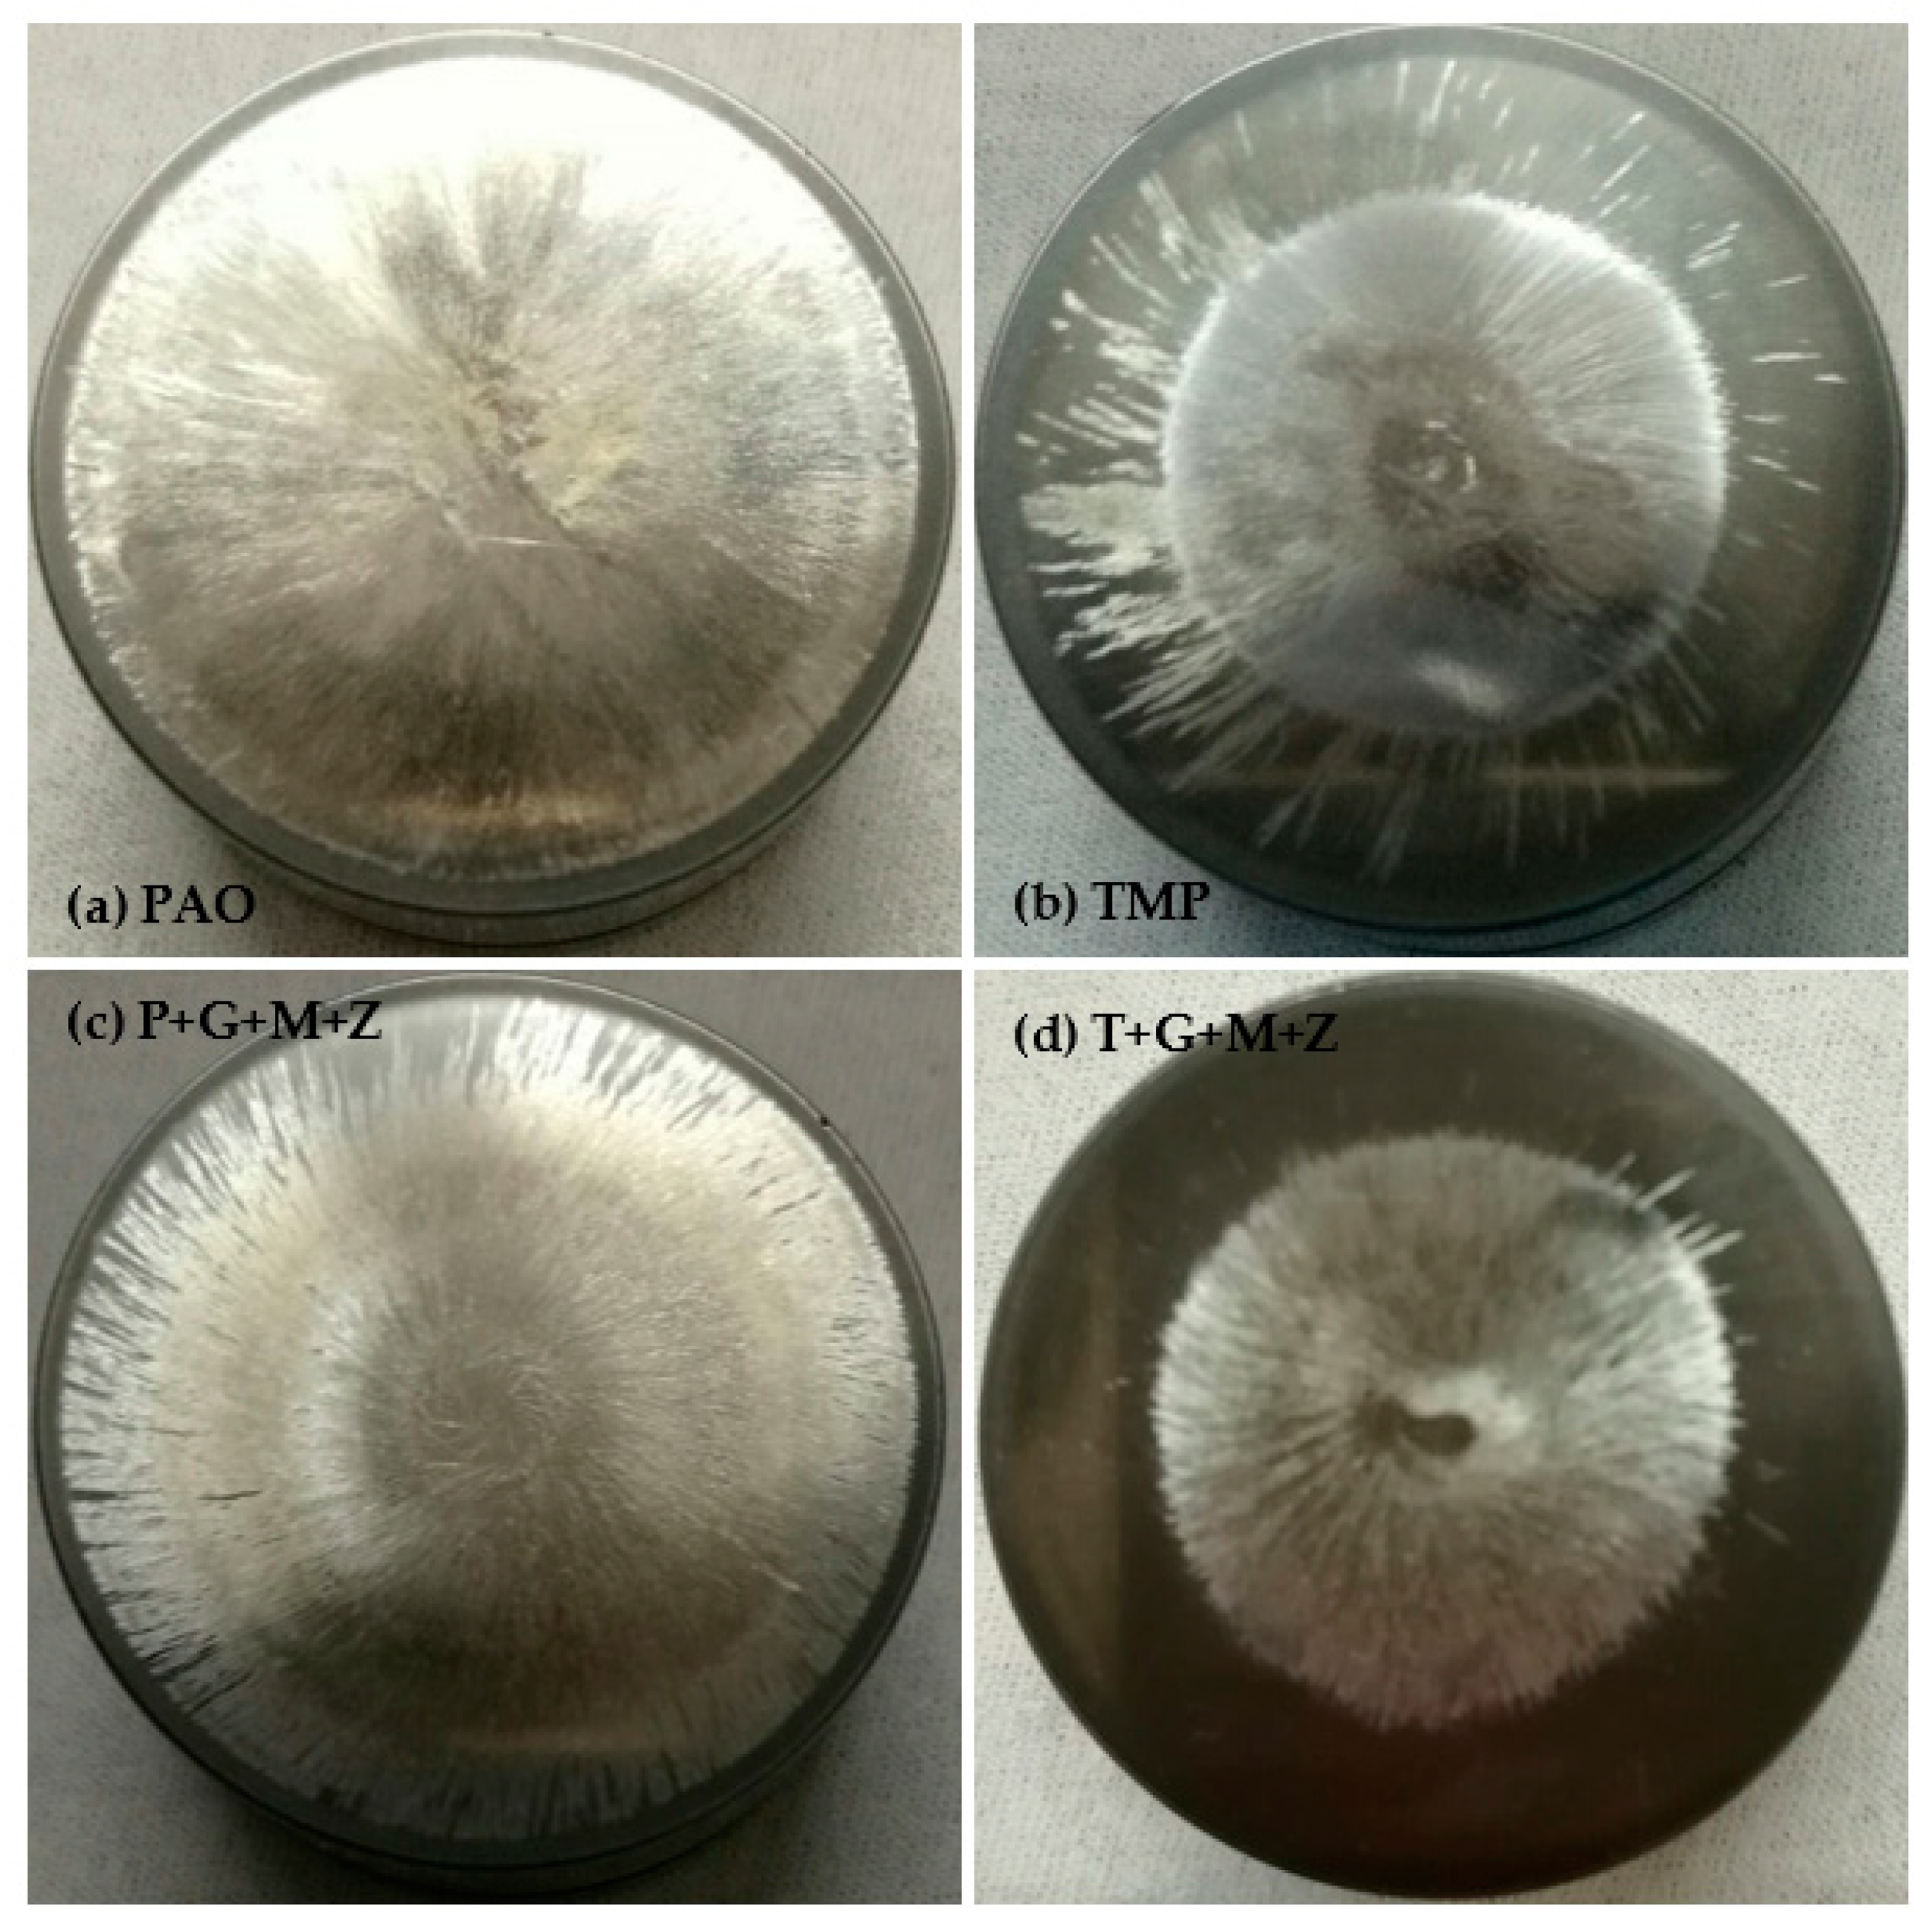
Materials 14 07206 g017

Friction and Wear Performance Evaluation of Bio-Lubricants and DLC Coatings on Cam/Tappet Interface of Internal Combustion Engines
Abstract
1. Introduction
2. Materials and Methods
2.1. Formulation of Lubricants
2.2. DLC Coating Specifications
2.3. Experimental Setup
2.4. Testing Procedure
2.5. Characterization of Worn Surfaces
3. Results and Discussion
3.1. Friction Analysis of the a-C:H-a-C:H Interface
3.2. Wear Analysis of the a-C:H-a-C:H Interface
3.3. SEM/EDS Analysis of the a-C:H-a-C:H Interface
3.4. Surface Roughness Analysis of a-C:H-Coated Tappet/a-C:H-Coated Camlobe (a-C:H-a-C:H)
3.5. Friction Analysis of the a-C:H:W-a-C:H:W Interface
3.6. Wear Analysis of a-C:H:W-Coated Tappet/a-C:H:W-Coated Camlobe (a-C:H:W-a-C:H:W)
3.7. SEM/EDS Analysis of the a-C:H:W-a-C:H:W Interface
3.8. Surface Roughness Analysis of the a-C:H:W-a-C:H:W Interface
4. Conclusions
Author Contributions
Funding
Institutional Review Board Statement
Informed Consent Statement
Data Availability Statement
Conflicts of Interest
References
- Kalin, M.; Velkavrh, I.; Vižintin, J.; Ožbolt, L. Review of boundary lubrication mechanisms of DLC coatings used in mechanical applications. Meccanica 2008, 43, 623–637. [Google Scholar] [CrossRef]
- Abdullah, M.U.; Shah, S.R.; Bhutta, M.U.; Mufti, R.A.; Khurram, M.; Najeeb, M.H.; Arshad, W.; Ogawa, K. Benefits of wonder process craft on engine valve train performance. Proc. Inst. Mech. Eng. Part D J. Automob. Eng. 2018, 233, 1125–1135. [Google Scholar] [CrossRef]
- Bhutta, M.U.; Khan, Z.A. Wear and friction performance evaluation of nickel based nanocomposite coatings under refrigerant lubrication. Tribol. Int. 2020, 148, 106312. [Google Scholar] [CrossRef]
- Bhutta, M.U.; Khan, Z.A.; Garland, N. Wear Performance Analysis of Ni–Al2O3 Nanocomposite Coatings under Nonconventional Lubrication. Materials 2019, 12, 36. [Google Scholar] [CrossRef]
- Bewilogua, K.; Hofmann, D. History of diamond-like carbon films—From first experiments to worldwide applications. Surf. Coat. Technol. 2014, 242, 214–225. [Google Scholar] [CrossRef]
- Oksanen, J.; Hakala, T.J.; Tervakangas, S.; Laakso, P.; Kilpi, L.; Ronkainen, H.; Koskinen, J. Tribological properties of laser-textured and ta-C coated surfaces with burnished WS2 at elevated temperatures. Tribol. Int. 2014, 70, 94–103. [Google Scholar] [CrossRef]
- Deng, X.; Kousaka, H.; Tokoroyama, T.; Umehara, N. Tribological behavior of tetrahedral amorphous carbon (ta-C) coatings at elevated temperatures. Tribol. Int. 2014, 75, 98–103. [Google Scholar] [CrossRef]
- Tasdemir, H.A.; Wakayama, M.; Tokoroyama, T.; Kousaka, H.; Umehara, N.; Mabuchi, Y.; Higuchi, T. The effect of oil temperature and additive concentration on the wear of non-hydrogenated DLC coating. Tribol. Int. 2014, 77, 65–71. [Google Scholar] [CrossRef]
- Erdemir, A.; Donnet, C. Tribology of diamond-like carbon films: Recent progress and future prospects. J. Phys. D Appl. Phys. 2006, 39, R311–R327. [Google Scholar] [CrossRef]
- Sanchez-Lopez, J.C.; Erdemir, A.; Donnet, C.; Rojas, T.C. Friction-induced structural transformations of diamondlike carbon coatings under various atmospheres. Surf. Coat. Technol. 2003, 163, 444–450. [Google Scholar] [CrossRef]
- Grischke, M.; Hieke, A.; Morgenweck, F.; Dimigen, H. Variation of the wettability of DLC-coatings by network modification using silicon and oxygen. Diam. Relat. Mater. 1998, 7, 454–458. [Google Scholar] [CrossRef]
- Donnet, C. Recent progress on the tribology of doped diamond-like and carbon alloy coatings: A review. Surf. Coat. Technol. 1998, 100–101, 180–186. [Google Scholar] [CrossRef]
- Cutiongco, E.C.; Li, D.; Chung, Y.W.; Bhatia, C.S. Tribological behavior of amorphous carbon nitride overcoats for magnetic thin-film rigid disks. J. Tribol. 1996, 118, 543–548. [Google Scholar] [CrossRef]
- Qian, F.; Craciun, V.; Singh, R.K.; Dutta, S.D.; Pronko, P.P. High intensity femtosecond laser deposition of diamond-like carbon thin films. J. Appl. Phys. 1999, 86, 2281–2290. [Google Scholar] [CrossRef]
- Garrelie, F.; Loir, A.S.; Donnet, C.; Rogemond, F.; Le Harzic, R.; Belin, M.; Audouard, E.; Laporte, P. Femtosecond pulsed laser deposition of diamond-like carbon thin films for tribological applications. Surf. Coat. Technol. 2003, 163, 306–312. [Google Scholar] [CrossRef]
- McNutt, J.; He, Q. Development of biolubricants from vegetable oils via chemical modification. J. Ind. Eng. Chem. 2016, 36, 1–12. [Google Scholar] [CrossRef]
- Erhan, S.Z.; Sharma, B.K.; Perez, J.M. Oxidation and low temperature stability of vegetable oil-based lubricants. Ind. Crop. Prod. 2006, 24, 292–299. [Google Scholar] [CrossRef]
- Liu, Z.; Sharma, B.K.; Erhan, S.Z.; Biswas, A.; Wang, R.; Schuman, T.P. Oxidation and low temperature stability of polymerized soybean oil-based lubricants. Thermochim. Acta 2015, 601, 9–16. [Google Scholar] [CrossRef]
- Sharma, B.K.; Adhvaryu, A.; Erhan, S.Z. Friction and wear behavior of thioether hydroxy vegetable oil. Tribol. Int. 2009, 42, 353–358. [Google Scholar] [CrossRef]
- Mobarak, H.M.; Mohamad, E.N.; Masjuki, H.H.; Kalam, M.A.; Al Mahmud, K.A.H.; Habibullah, M.; Ashraful, A.M. The prospects of biolubricants as alternatives in automotive applications. Renew. Sustain. Energy Rev. 2014, 33, 34–43. [Google Scholar] [CrossRef]
- Wagner, H.; Luther, R.; Mang, T. Lubricant base fluids based on renewable raw materials: Their catalytic manufacture and modification. Appl. Catal. A Gen. 2001, 221, 429–442. [Google Scholar] [CrossRef]
- Jayadas, N.H.; Nair, K.P.; Ajithkumar, G. Tribological evaluation of coconut oil as an environment-friendly lubricant. Tribol. Int. 2007, 40, 350–354. [Google Scholar] [CrossRef]
- He, Z.; Lu, J.; Zeng, X.; Shao, H.; Ren, T.; Liu, W. Study of the tribological behaviors of S, P-containing triazine derivatives as additives in rapeseed oil. Wear 2004, 257, 389–394. [Google Scholar] [CrossRef]
- Alves, S.M.; Barros, B.S.; Trajano, M.F.; Ribeiro, K.S.B.; Moura, E.J.T.I. Tribological behavior of vegetable oil-based lubricants with nanoparticles of oxides in boundary lubrication conditions. Tribol. Int. 2013, 65, 28–36. [Google Scholar] [CrossRef]
- Arumugam, S.; Sriram, G. Synthesis and characterization of rapeseed oil bio-lubricant dispersed with nano copper oxide: Its effect on wear and frictional behavior of piston ring-cylinder liner combination. Proc. Inst. Mech. Eng. Part J J. Eng. Tribol. 2014, 228, 1308–1318. [Google Scholar] [CrossRef]
- Zulkifli, N.W.M.; Kalam, M.A.; Masjuki, H.H.; Al Mahmud, K.A.H.; Yunus, R. The Effect of Temperature on Tribological Properties of Chemically Modified Bio-Based Lubricant. Tribol. Trans. 2014, 57, 408–415. [Google Scholar] [CrossRef]
- Zulkifli, N.W.M.; Kalam, M.A.; Masjuki, H.H.; Shahabuddin, M.; Yunus, R. Wear prevention characteristics of a palm oil-based TMP (trimethylolpropane) ester as an engine lubricant. Energy 2013, 54, 167–173. [Google Scholar] [CrossRef]
- Yunus, R.; Fakhru’l-Razi, A.; Ooi, T.L.; Iyuke, S.E.; Perez, J.M. Lubrication properties of trimethylolpropane esters based on palm oil and palm kernel oils. Eur. J. Lipid Sci. Technol. 2004, 106, 52–60. [Google Scholar] [CrossRef]
- Reddy, K.S.V.K.; Kabra, N.; Kunchum, U.; Vijayakumar, T. Experimental Investigation on Usage of Palm Oil as a Lubricant to Substitute Mineral Oil in CI Engines. Chin. J. Eng. 2014, 2014, 643521. [Google Scholar] [CrossRef]
- Zahid, R.; Hassan, M.B.H.; Alabdulkarem, A.; Varman, M.; Mufti, R.A.; Kalam, M.A.; Zulkifli, N.W.B.M.; Gulzar, M.; Lee, T. Investigation of the tribochemical interactions of a tungsten-doped diamond-like carbon coating (W-DLC) with formulated palm trimethylolpropane ester (TMP) and polyalphaolefin (PAO). RSC Adv. 2017, 7, 26513–26531. [Google Scholar] [CrossRef]
- Zahid, R.; Hassan, M.B.H.; Varman, M.; Mufti, R.A.; Kalam, M.A.; Zulkifli, N.W.B.M.; Gulzar, M. A Review on Effects of Lubricant Formulations on Tribological Performance and Boundary Lubrication Mechanisms of Non-Doped DLC/DLC Contacts. Crit. Rev. Solid State Mater. Sci. 2016, 42, 267–294. [Google Scholar] [CrossRef]
- Zahid, R.; Hassan, M.H.; Alabdulkarem, A.; Varman, M.; Kalam, M.A.; Mufti, R.A.; Zulkifli, N.W.M.; Gulzar, M.; Bhutta, M.U.; Ali, M.A.; et al. Tribological characteristics comparison of formulated palm trimethylolpropane ester and polyalphaolefin for cam/tappet interface of direct acting valve train system. Ind. Lubr. Tribol. 2018, 70, 888–901. [Google Scholar] [CrossRef]
- Zahid, R.; Masjuki, H.H.; Varman, M.; Kalam, M.A.; Mufti, R.A.; Zulkifli, N.W.B.M.; Gulzar, M.; Azman, S.S.B.N. Influence of intrinsic and extrinsic conditions on the tribological characteristics of diamond-like carbon coatings: A review. J. Mater. Res. 2016, 31, 1814–1836. [Google Scholar] [CrossRef]
- Zahid, R.; Masjuki, H.H.; Varman, M.; Mufti, R.A.; Kalam, M.A.; Gulzar, M. Effect of Lubricant Formulations on the Tribological Performance of Self-Mated Doped DLC Contacts: A review. Tribol. Lett. 2015, 58, 32. [Google Scholar] [CrossRef]
- Arshad, W.; Hanif, M.A.; Bhutta, M.U.; Mufti, R.A.; Shah, S.R.; Abdullah, M.U.; Najeeb, M.H. Technique developed to study camshaft and tappet wear on real production engine. Ind. Lubr. Tribol. 2017, 69, 174–181. [Google Scholar] [CrossRef]
- Mufti, R.A.; Priest, M. Experimental and theoretical study of instantaneous engine valve train friction. J. Tribol. 2003, 125, 628–637. [Google Scholar] [CrossRef]
- Baniasad, S.M.; Emes, M.R. Design and development of method of valve-train friction measurement. No. 980572. J. Engines 1998, 107, 864–880. [Google Scholar]
- Al Mahmud, K.A.H.; Varman, M.; Kalam, M.A.; Masjuki, H.H.; Mobarak, H.M.; Zulkifli, N.W.M. Tribological characteristics of amorphous hydrogenated (aC: H) and tetrahedral (ta-C) diamond-like carbon coating at different test temperatures in the presence of commercial lubricating oil. Surf. Coat. Technol. 2014, 245, 133–147. [Google Scholar] [CrossRef]
- Wardhani, R.; Rahadian, Y. Sustainability strategy of Indonesian and Malaysian palm oil industry: A qualitative analysis. Sustain. Account. Manag. Policy J. 2021, 12, 1077–1107. [Google Scholar]
- Kannan, P.; Mansor, N.H.; Rahman, N.K.; PENG, T.; Mazlan, S.M. A review on the malaysian sustainable palm oil certification process among independent oil palm smallholders. J. Oil Palm Res. 2021, 33, 171–180. [Google Scholar] [CrossRef]

| Lubricants | Formulation Details | Physicochemical Properties | ||||||
|---|---|---|---|---|---|---|---|---|
| TMP (wt.%) | PAO (wt.%) | GMO (wt.%) | MoDTC (wt.%) | ZDDP (wt.%) | Kinematic Viscosity at 100 °C (cSt) | Viscosity Index | Density (g/cm3) | |
| TMP | 100 | - | - | - | - | 9.33 | 194.50 | 0.92 |
| PAO | - | 100 | - | - | - | 9.85 | 135.40 | 0.84 |
| TMP+GMO+MoDTC+ZDDP (T+G+M+Z) | 97 | - | 1 | 1 | 1 | 9.84 | 193.24 | 0.92 |
| PAO+GMO+MoDTC+ZDDP (P+G+M+Z) | - | 97 | 1 | 1 | 1 | 9.98 | 135.34 | 0.838 |
| Properties | a-C:H | a-C:H:W |
|---|---|---|
| Deposition technique | PACVD combined with ion sputtering | PVD combined with ion sputtering |
| Interlayer | CrN | CrN |
| Thickness | 2–3 µm | 2–3 µm |
| Average surface roughness | 0.02–0.03 µm | 0.02–0.03 µm |
| Hardness | 15–25 GPa | 12–15 GPa |
| Maximum service temperature | 300 °C | 300 °C |
| Color | Black | Anthracite |
| Manufacturer | Daimler |
| Displacement | 2148 cubic centimeter (cc) |
| Fuel | Common rail diesel direct injection |
| Induction | Turbocharged |
| Number of cylinders | 4′ |
| Cylinder configuration | In-line |
| Emission compliance level | Euro IV |
| Exhaust post-treatment method | Oxidation catalyst converter (Oxy-Cat)/diesel particulate filter (DPF) |
| Test No. | Lubricant | Tribopair | Lubricant Temperature | Camshaft Speeds |
|---|---|---|---|---|
| New uncoated camlobe/uncoated tappet pair and fresh additive-free PAO | ||||
| 1. | PAO | Uncoated cam/uncoated tappet | 40 °C | 400 RPM, 800 RPM, and 1200 RPM |
| 2. | PAO | Uncoated cam/uncoated tappet | 90 °C | 400 RPM, 800 RPM, and 1200 RPM |
| New a-C:H-coated camlobe/a-C:H-coated tappet pair | ||||
| 3. | PAO | a-C:H-coated camlobe/a-C:H-coated tappet | 40 °C | 400 RPM, 800 RPM, and 1200 RPM |
| 4. | PAO | a-C:H-coated camlobe/a-C:H-coated tappet | 90 °C | 400 RPM, 800 RPM, and 1200 RPM |
| New a-C:H:W-coated camlobe/a-C:H:W-coated tappet pair | ||||
| 5. | PAO | a-C:H:W-coated camlobe/a-C:H:W-coated tappet | 40 °C | 400 RPM, 800 RPM, and 1200 RPM |
| 6. | PAO | a-C:H:W-coated camlobe/a-C:H:W-coated tappet | 90 °C | 400 RPM, 800 RPM, and 1200 RPM |
| New uncoated camlobe/uncoated tappet pair and fresh additive-free TMP | ||||
| 7. | TMP | Uncoated cam/uncoated tappet | 40 °C | 400 RPM, 800 RPM, and 1200 RPM |
| 8. | TMP | Uncoated cam/uncoated tappet | 90 °C | 400 RPM, 800 RPM, and 1200 RPM |
| New a-C:H-coated camlobe/a-C:H-coated tappet pair | ||||
| 9. | TMP | a-C:H-coated camlobe/a-C:H-coated tappet | 40 °C | 400 RPM, 800 RPM, and 1200 RPM |
| 10. | TMP | a-C:H-coated camlobe/a-C:H-coated tappet | 90 °C | 400 RPM, 800 RPM, and 1200 RPM |
| New a-C:H:W-coated camlobe/a-C:H:W-coated tappet pair | ||||
| 11. | TMP | a-C:H:W-coated camlobe/a-C:H:W-coated tappet | 40 °C | 400 RPM, 800 RPM, and 1200 RPM |
| 12. | TMP | a-C:H:W-coated camlobe/a-C:H:W-coated tappet | 90 °C | 400 RPM, 800 RPM, and 1200 RPM |
| New uncoated camlobe/uncoated tappet pair and formulated TMP (T+G+M+Z) | ||||
| 13. | T+G+M+Z | Uncoated cam/uncoated tappet | 40 °C | 400 RPM, 800 RPM, and 1200 RPM |
| 14. | T+G+M+Z | Uncoated cam/uncoated tappet | 90 °C | 400 RPM, 800 RPM, and 1200 RPM |
| New a-C:H-coated camlobe/a-C:H-coated tappet pair | ||||
| 15. | T+G+M+Z | a-C:H-coated camlobe/a-C:H-coated tappet | 40 °C | 400 RPM, 800 RPM, and 1200 RPM |
| 16. | T+G+M+Z | a-C:H-coated camlobe/a-C:H-coated tappet | 90 °C | 400 RPM, 800 RPM, and 1200 RPM |
| New a-C:H:W-coated camlobe/a-C:H:W-coated tappet pair | ||||
| 17. | T+G+M+Z | a-C:H:W-coated camlobe/a-C:H:W-coated tappet | 40 °C | 400 RPM, 800 RPM, and 1200 RPM |
| 18. | T+G+M+Z | a-C:H:W-coated camlobe/a-C:H:W-coated tappet | 90 °C | 400 RPM, 800 RPM, and 1200 RPM |
| New uncoated camlobe/uncoated tappet pair and fresh formulated PAO (P+G+M+Z) | ||||
| 19. | P+G+M+Z | Uncoated cam/uncoated tappet | 40 °C | 400 RPM, 800 RPM, and 1200 RPM |
| 20. | P+G+M+Z | Uncoated cam/uncoated tappet | 90 °C | 400 RPM, 800 RPM, and 1200 RPM |
| New a-C:H-coated camlobe/a-C:H-coated tappet pair | ||||
| 21. | P+G+M+Z | a-C:H-coated camlobe/a-C:H-coated tappet | 40 °C | 400 RPM, 800 RPM, and 1200 RPM |
| 22. | P+G+M+Z | a-C:H-coated camlobe/a-C:H-coated tappet | 90 °C | 400 RPM, 800 RPM, and 1200 RPM |
| New a-C:H:W-coated camlobe/a-C:H:W-coated tappet pair | ||||
| 23. | P+G+M+Z | a-C:H:W-coated camlobe/a-C:H:W-coated tappet | 40 °C | 400 RPM, 800 RPM, and 1200 RPM |
| 24. | P+G+M+Z | a-C:H:W-coated camlobe/a-C:H:W-coated tappet | 90 °C | 400 RPM, 800 RPM, and 1200 RPM |
| Lubricants | Elements | |||||||||
|---|---|---|---|---|---|---|---|---|---|---|
| C | Cr | N | P | S | Mo | Zn | Fe | O | Ar | |
| PAO | 97.07 | - | - | - | - | - | - | - | 2.52 | 0.41 |
| TMP | 64.52 | 7.61 | 3.41 | - | - | - | - | 11.72 | 12.74 | - |
| P+G+M+Z | 94.41 | 0.67 | - | 0.12 | 0.32 | 1.66 | 1.33 | - | 1.49 | - |
| T+G+M+Z | 79.33 | 7.94 | 2.98 | 0.12 | 0.25 | 1.03 | 0.37 | - | 7.98 | - |
| Lubricants | Elements | ||||||
|---|---|---|---|---|---|---|---|
| C | W | Cr | N | Fe | O | Ni | |
| PAO | 35.3 | 7.3 | 4.8 | 6.0 | 32.5 | 10.7 | 3.4 |
| TMP | 60.1 | 14.9 | 6.2 | 2.4 | 2.7 | 9.0 | 4.6 |
| P+G+M+Z | 39.6 | 11.5 | 10.1 | 9.2 | 21.9 | 3.4 | 4.2 |
| T+G+M+Z | 11.9 | 0.4 | 11.0 | 10.7 | 57.3 | 8.7 | - |
Publisher’s Note: MDPI stays neutral with regard to jurisdictional claims in published maps and institutional affiliations. |
© 2021 by the authors. Licensee MDPI, Basel, Switzerland. This article is an open access article distributed under the terms and conditions of the Creative Commons Attribution (CC BY) license (https://creativecommons.org/licenses/by/4.0/).
Share and Cite
Zahid, R.; Bhutta, M.U.; Mufti, R.A.; Abdullah, M.U.; Masjuki, H.H.; Varman, M.; Kalam, M.A.; Ali, M.A.; Aslam, J.; Akhtar, K. Friction and Wear Performance Evaluation of Bio-Lubricants and DLC Coatings on Cam/Tappet Interface of Internal Combustion Engines. Materials 2021, 14, 7206. https://doi.org/10.3390/ma14237206
Zahid R, Bhutta MU, Mufti RA, Abdullah MU, Masjuki HH, Varman M, Kalam MA, Ali MA, Aslam J, Akhtar K. Friction and Wear Performance Evaluation of Bio-Lubricants and DLC Coatings on Cam/Tappet Interface of Internal Combustion Engines. Materials. 2021; 14(23):7206. https://doi.org/10.3390/ma14237206
Chicago/Turabian StyleZahid, Rehan, Muhammad Usman Bhutta, Riaz Ahmad Mufti, Muhammad Usman Abdullah, Haji Hassan Masjuki, Mahendra Varman, Muhammad Abul Kalam, Mian Ashfaq Ali, Jawad Aslam, and Khalid Akhtar. 2021. "Friction and Wear Performance Evaluation of Bio-Lubricants and DLC Coatings on Cam/Tappet Interface of Internal Combustion Engines" Materials 14, no. 23: 7206. https://doi.org/10.3390/ma14237206
APA StyleZahid, R., Bhutta, M. U., Mufti, R. A., Abdullah, M. U., Masjuki, H. H., Varman, M., Kalam, M. A., Ali, M. A., Aslam, J., & Akhtar, K. (2021). Friction and Wear Performance Evaluation of Bio-Lubricants and DLC Coatings on Cam/Tappet Interface of Internal Combustion Engines. Materials, 14(23), 7206. https://doi.org/10.3390/ma14237206

